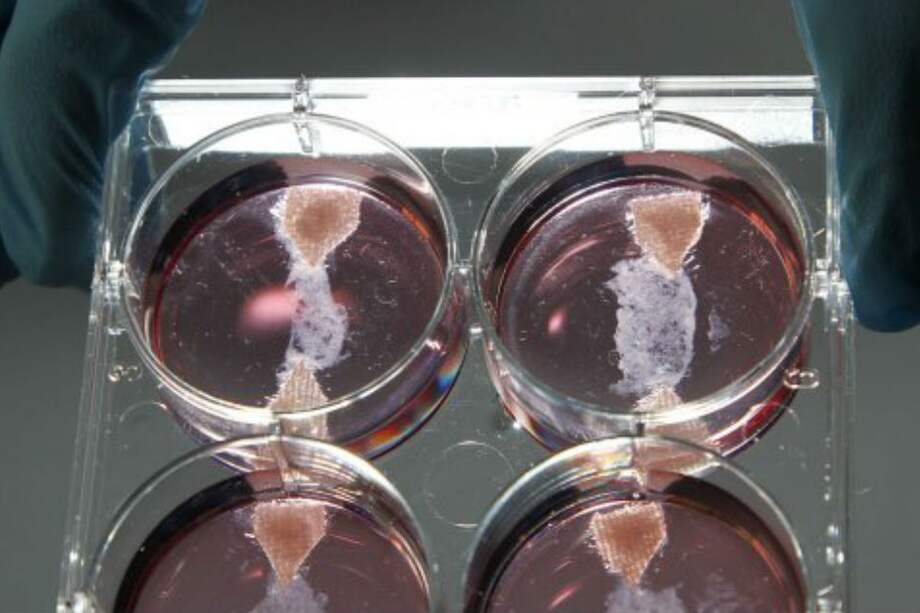
Presentan la primera hamburguesa creada en laboratorio

Escucha este artículo
Audio generado con IA de Google
0:00
/
0:00
Científicos holandeses presentaron en Londres la primera hamburguesa creada y desarrollada artificialmente en un laboratorio a partir de células madre vacunas.
La revolucionaria hamburguesa se degustó en una rueda de prensa en Londres que sirvió para presentar el avance y explicar cómo el grupo de expertos liderados por Mark Post, de la Universidad de Maastrich, sacó adelante este proyecto, que ha costado casi 250.000 euros aportados por Sergey Brin, cofundador de Google.
A partir de células madre de vaca, los científicos consiguieron multiplicar sus muestras tras alimentar con nutrientes las células y acelerar su crecimiento mediante sustancias químicas.
Después de tres semanas de proceso continuado, obtuvieron más de un millón de células madre que fueron apartadas en pequeños recipientes donde se fusionaron hasta formar minúsculas tiras de músculo, de aproximadamente un centímetro de largo y varios milímetros de ancho.
Una vez conseguidas 20.000 de estas tiras, se congelaron para más tarde pasarlas a temperatura ambiente y convertirlas en una masa compacta de hamburguesa que puede ser cocinada y en cuya elaboración participan decenas de millones de células madre, según el profesor Post.
En rueda de prensa en Londres, los científicos advirtieron sin embargo de que aún se trabaja para darle un aspecto más auténtico, puesto que la carne procedente del laboratorio es blanca y su sabor todavía "no es lo bastante bueno", en palabras del jefe de equipo.
Los expertos apuntaron, además, que el desarrollo de esta nueva técnica podría convertirse en una buena solución a la escasez alimentaria de carne en un futuro, además de suponer una alternativa viable para los colectivos contrarios al consumo de carne por el sufrimiento que padecen los animales.
En Inglaterra y Holanda están desarrollando carne artificial a partir de células animales. Lea aquí la entrevista completa con Hanna Tuomisto, de la Universidad de Oxford, donde explica los efectos de la carne creada en laboratorio o in vitro en el medio ambiente.

